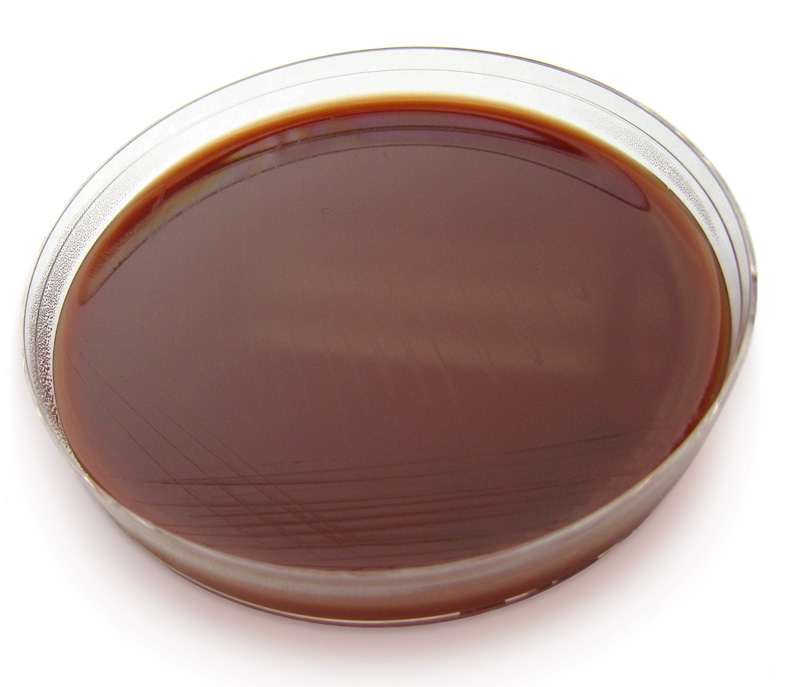

Category Weird facts

You are what you eat – or should our gut microbiome be considered an important body system in its own right?
Guest posting: Assoc. Prof. Josh Davis, Principal Research Fellow/NHMRC Career Development Fellow, Menzies School of Health Research, Senior Staff Specialist Infectious Diseases Physician, John Hunter Hospital, Conjoint Professor School of Medicine and Public Health, University of Newcastle The diverse bacterial communities which live in our gastrointestinal tract (primary in the colon), are collectively known as the “gut microbiota” and their collective […]

Revisiting #SaveTheScript 2015 – short film meets AMS
In 2015 NPS MedicineWise partnered with Tropfest, to launch a short film competition to raise awareness about antibiotic resistance. Here are our picks of the 15 finalists– definitely worth a revisit! First prize – “The Pick Up” of the not-so lovely Ms Gonorrhoea! “Antibiotic man” “Pills“ The #savethescript judging panel included: Dr Andrew Rochford, Seven Network Health Editor […]

Antibiotic Resistance: Facts and Figures
While we spend a lot of time talking about reducing antibiotic resistance it can difficult to get a feel for the size of the problem. The team at BioMerieux have put together some facts and figures that help quantify the problem.
Chocolate Agar for Easter
Chocolate agar is an enriched non specific growth medium which is used to grow and isolate pathogenic bacteria. Its also known as chocolate blood agar and is made using blood that has been slowly heated to 80 degrees. So probably not a great choice as a gift! Chocolate agar is a variant of blood agar […]

Paranoia 101 – where is it safe to put your hand?
A recent experiment mapped the bacterial travellers on the New York Subway system and found that grabbing a handrail transmits the same number of bacteria as shaking hands with 10 000 people. An average of 2 million colony forming units were found per square inch, which for frequent travellers, equates to 900 times more than airplane […]

Antimicrobial prophylaxis for leech therapy
Leeches have been used throughout history for a variety of different medical indications. Over exploitation of medical leech species throughout the 19th century lead to the species becoming threatened. Today medical leeches are breed in special populations. Medicinal leech therapy is increasing in popularity to assist in wound healing where venous congestion is a problem. Leeches […]

How did bacteria become resistant?
We all know that antibiotic resistance increases through improper use of antibiotics. With recent discoveries of bacteria containing antibiotic resistance genes in isolated tribes it would seem that bacteria have always been resistant- so why is it such a problem now?

Microbial Masterpieces
The American Society for Microbiology has recently held their Agar Art competition. This competition involves agar plates painted with cultures to make beautiful works of art.

Can you develop antibiotic resistance without antibiotics?
Studies of an indigenous tribe from the Amazon who had no previous contact with Europeans have shown you can!

Whip (flagellate) it good: the sound of a bacterium swimming
Scientists synthesise sound of single bacterium swimming – full story. Some mean machine! Dr Ashley Nord and Dr Matt Baker synthesised the sound of this whirring propeller when they attached microscopic polystyrene beads to the flagella of bacteria as part of their research into what makes them spin. The sound you can hear is perhaps more […]